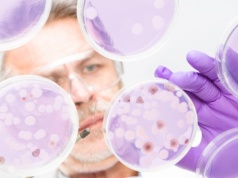
Naturalny kompas w bakteriach. Magnetosomy pomagają w orientacji

Doda udzieliła niegdyś słynnego wywiadu Karolinie Korwin Piotrowskiej i przyznała się w nim, że jest biseksualna. Teraz odniosła się do tych słów. Wyznała, że była kiedyś w związku z dziewczyną. Jak na to patrzy dziś?
źródło: https://jastrzabpost.pl/doda-wprost-o-swojej-orientacji-seksualnej-bylam-z-dziewczyna-kilka-lat,7253222112758144a
dodano: 11-02-2026 13:48:07
Inne znaleziska:
Siew z czubkiem w dół. Czy kontrola orientacji ziarna tip-down to kolejna rewolucja w siewnikach?
Siew z czubkiem w dół. Czy kontrola orientacji ziarna tip-down to kolejna rewolucja w siewnikach?
Precision Planting wprowadza system ArrowTube, który podczas siewu kukurydzy i soi ustawia każde ziarno w glebie „czubkiem w dół”. Producent obiecuje równiejsze wschody i lepsze wykorzystanie potencjału plonowania. Sprawdzamy, na czym polega technolo...
wrp.pl
12-02-2026 17:49:06
12-02-2026 17:49:06
Naturalny kompas w bakteriach. Magnetosomy pomagają w orientacji
Naturalny kompas w bakteriach. Magnetosomy pomagają w orientacji
Zespół naukowców z Uniwersytetu w Bazylei przyjrzał się bliżej bakterii Magnetospirillum gryphiswaldense, która potrafi orientować się zgodnie z polem magnetycznym Ziemi dzięki obecności magnetosomów. Badania pozwoliły określić siłę magnetyczną tych...
interia.pl
01-03-2026 07:42:06
01-03-2026 07:42:06
Doda idzie na wojnę ze Skolimem: "zajmij się sprzedawaniem swojej kiełbasy"
Doda idzie na wojnę ze Skolimem: "zajmij się sprzedawaniem swojej kiełbasy"
"W międzyczasie zapraszamy cię do teatru, musicalu, do miejsc, gdzie są artyści, którzy nie mieli jak prze********ć swoich finansów, bo po prostu ich nie mieli".
donald.pl
01-06-2026 19:29:07
01-06-2026 19:29:07
Ekspertka o przemocy seksualnej wobec kobiet: możemy wyłącznie szacować skalę
Ekspertka o przemocy seksualnej wobec kobiet: możemy wyłącznie szacować skalę
Człowiek jest wolny w różnych sferach życia. Jedną z tych sfer jest właśnie wolność seksualna. Kiedy dochodzi do naruszenia w tym zakresie, możemy mówić już o przemocy seksualnej - tłumaczy prof. Ewa Monika Guzik-Makaruk, ekspertka Katedry Prawa Karn...
rynekzdrowia.pl
19-07-2025 13:16:05
19-07-2025 13:16:05
"Zrobiłam to, czego nauczyła mnie matka". Królowa Kamila była ofiarą napaści seksualnej jako nastola...
"Zrobiłam to, czego nauczyła mnie matka". Królowa Kamila była ofiarą napaści seksualnej jako nastolatka
Pałac Buckingham nie wydał oficjalnego oświadczenia w sprawie napaści, jakiej miała doświadczyć królowa Kamila, ale też nie zakwestionował szczegółów relacji przedstawionej na łamach "Sunday Times".
wysokieobcasy.pl
01-09-2025 12:43:06
01-09-2025 12:43:06
Funkcjonariusz policji usłyszał zarzut popełnienia przestępstwa przeciwko wolności seksualnej
Funkcjonariusz policji usłyszał zarzut popełnienia przestępstwa przeciwko wolności seksualnej
Funkcjonariusz policji usłyszał zarzut popełnienia przestępstwa przeciwko wolności seksualnej i obyczajowości. Jest podejrzany o to, że doprowadził kobietę do poddania się innej czynności seksualnej wbrew jej woli. Do zdarzenia miało dojść w nocy z 3...
gazetastonoga.com.pl
05-09-2025 01:37:07
05-09-2025 01:37:07
"Straszono, że zajdę w ciążę od trzymania się za rękę". Dorastanie bez edukacji seksualnej
"Straszono, że zajdę w ciążę od trzymania się za rękę". Dorastanie bez edukacji seksualnej
— Straszono mnie, że zajdę w ciążę od trzymania się za rękę — wspomina Alicja. — Wiedzę czerpałam z filmów dla dorosłych, od których się uzależniłam — dodaje Julia. Kasia pamięta tylko zażenowanie, gdy matka pytała, czy "na całowaniu się kończy". To...
noizz.pl
17-09-2025 11:20:24
17-09-2025 11:20:24
"Straszyli, że zajdę w ciążę od trzymania się za rękę". Dorastanie bez edukacji seksualnej
"Straszyli, że zajdę w ciążę od trzymania się za rękę". Dorastanie bez edukacji seksualnej
— Straszono mnie, że zajdę w ciążę od trzymania się za rękę — wspomina Alicja. — Wiedzę czerpałam z filmów dla dorosłych, od których się uzależniłam — dodaje Julia. Kasia pamięta tylko zażenowanie, gdy matka pytała, czy "na całowaniu się kończy". To...
noizz.pl
17-09-2025 13:29:23
17-09-2025 13:29:23
Pedofilia, obrona homoseksualizmu i… post-marksizm: paskudny rodowód edukacji seksualnej
Pedofilia, obrona homoseksualizmu i… post-marksizm: paskudny rodowód edukacji seksualnej
Polscy uczniowie – ci, których rodzice nie wypisali z zajęć – uczestniczą w lekcjach nowego przedmiotu: edukacji zdrowotnej. Elementem dedykowanej mu podstawy programowej jest między innymi nauka akceptacji dla „różnorodności seksualnej”. Za tym nies...
pch24.pl
21-10-2025 07:36:21
21-10-2025 07:36:21
Neil Gaiman zaprzecza zarzutom napaści seksualnej i nazywa te zarzuty "kampanią oszczerstw"
Neil Gaiman zaprzecza zarzutom napaści seksualnej i nazywa te zarzuty "kampanią oszczerstw"
Autor Neil Gaiman publicznie odniósł się do licznych zarzutów o napaść seksualną, nazywając je "całkowicie i po prostu nieprawdziwymi" i twierdząc, że jest celem "kampanii oszczerstów". 65-letni pisarz, znany z takich prac jak American Gods, wygłosił...
gamereactor.pl
03-02-2026 08:04:03
03-02-2026 08:04:03